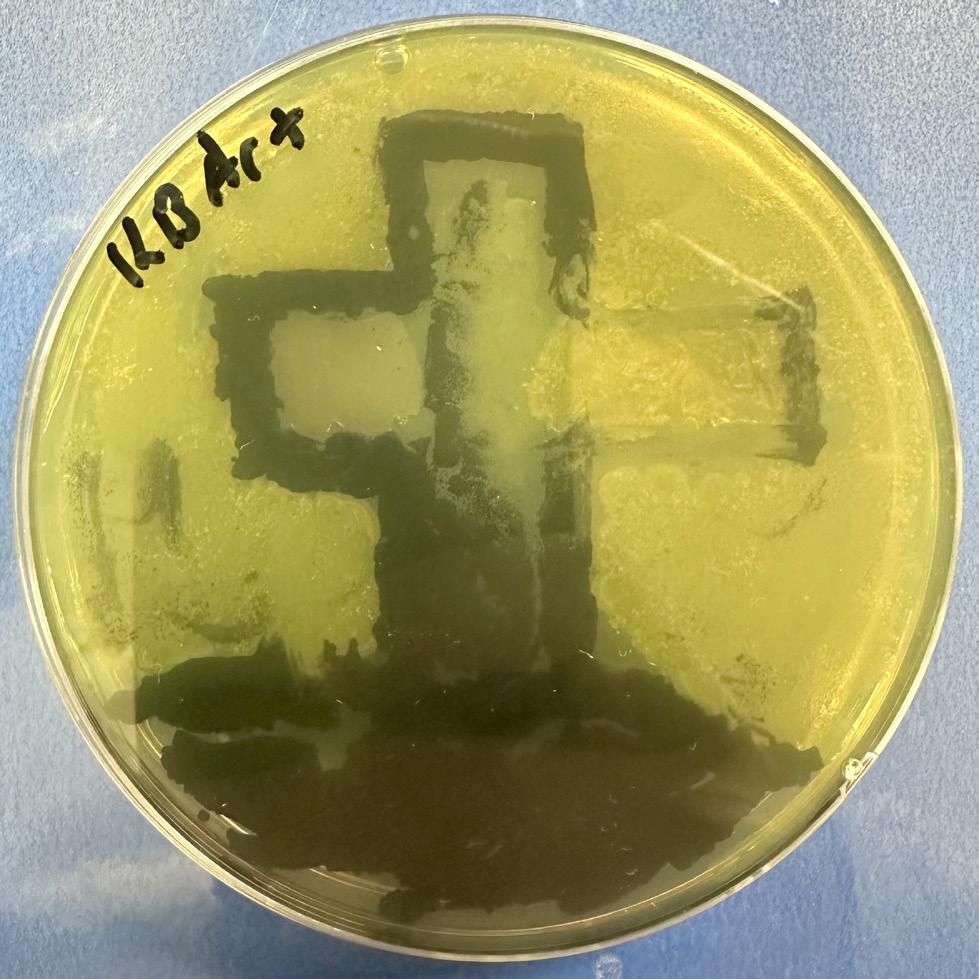
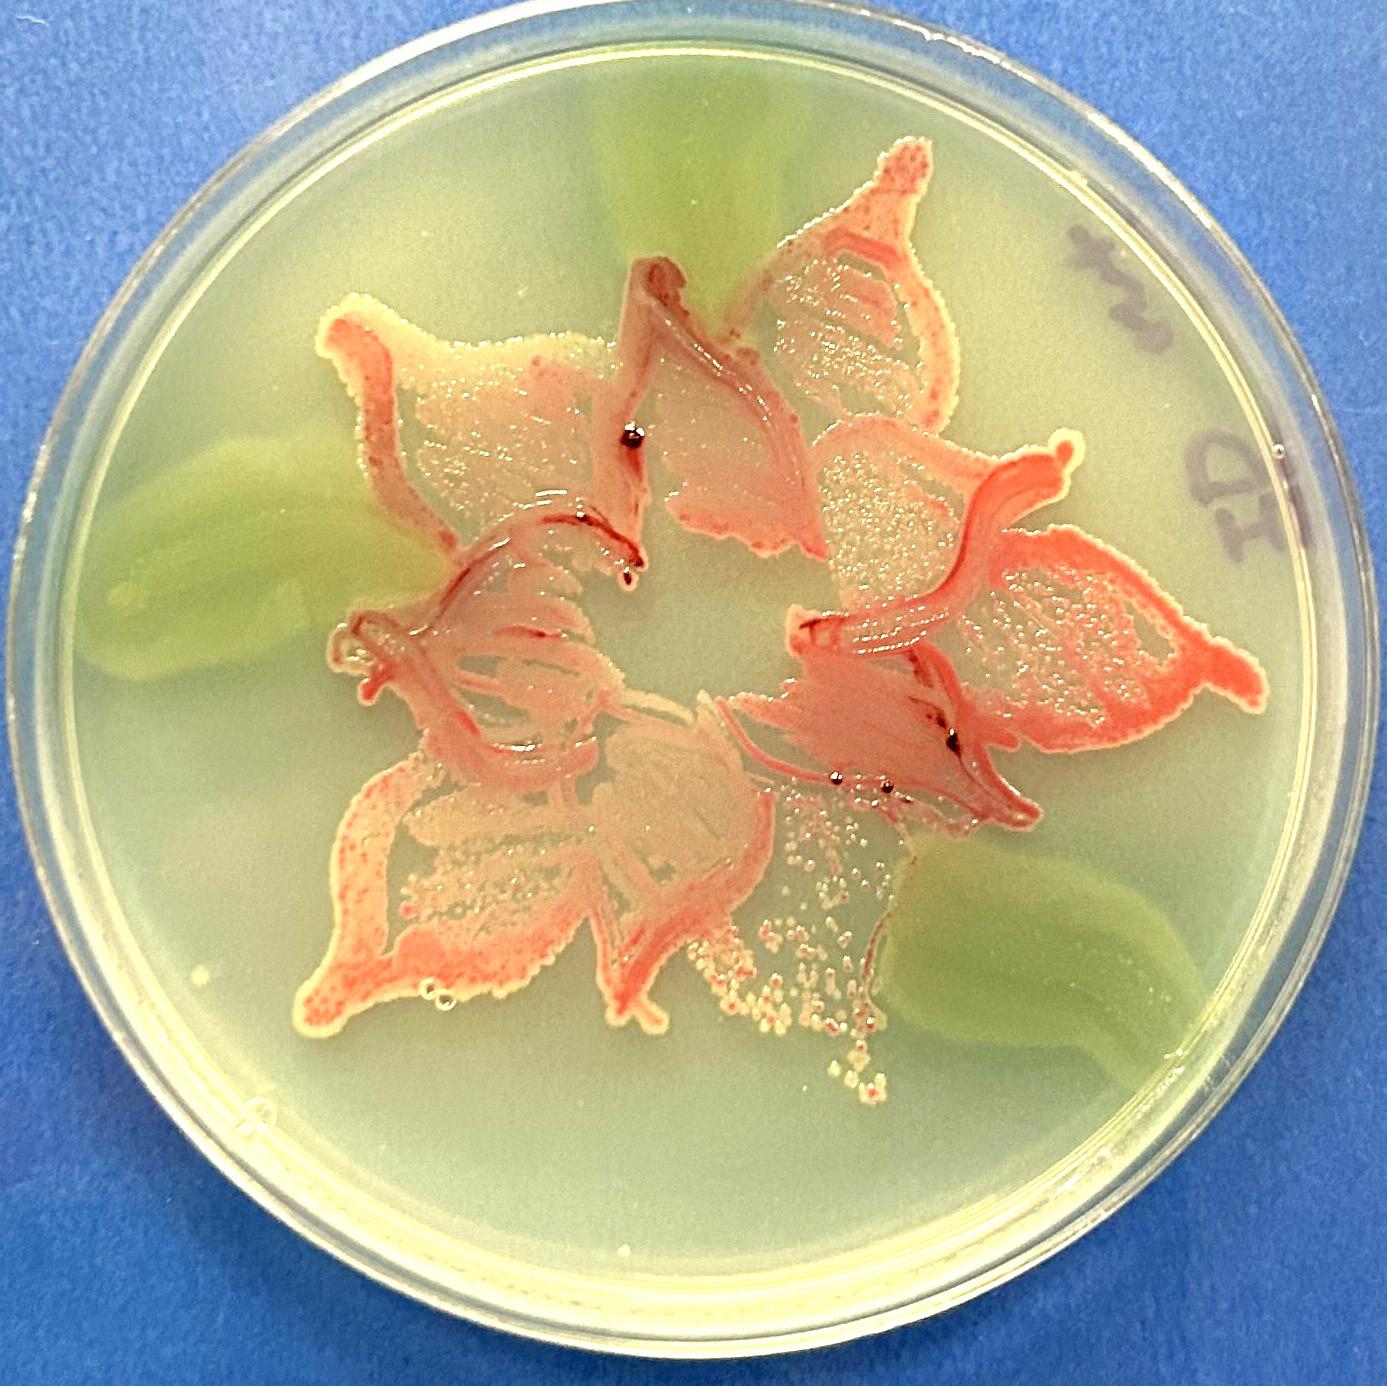

EDITOR
Sophia Messenger
ASSISTANT EDITORS
Jada Abrams
Diego Casillas
Thomas Caulfield
Savanna Greene
Alex Hamilton
Cadence Hoover
Dale Hyland
Maeve McCormick
Alina Stiger
ADVISORS
Clayton Bradshaw-Mittal, Ph.D.
Assistant Professor, English
THE JUDGING PROCESS
BOOK DESIGN
Andrew Lapiska Director, Marketing & Communications
COVER ARTWORK
Amaan Khan
POETRY/PROSE JUDGES
Clayton Bradshaw-Mittal, Ph.D.
Assistant Professor, English
Ann Bomberger, Ph.D.
Associate Professor, English
Derek DiMatteo, Ph.D.
Assistant Professor, English
Great care was taken to select the written and artistic works that are published in Totem. All work was judged anonymously on its literary and artistic merit. The judging panel for the written work consisted of undergraduate and faculty members. The authors’ names were concealed during the reading process, and judges recused themselves if they recognized the work. After reading and re-reading the submissions, the judges met to discuss each submission one by one to choose those that best represent the university. For the art, a mix of students and faculty members scored their choices of work, which also had the names of the artists removed.
This year, we included a special category for agar art from a microbiology lab run by Dr. Gary Vanderlaan and Dr. Matthew Gacura. Students used living paint in the form of colorful bacteria to paint a blank canvas made up of nutrient agar in a petri dish. Then, they let their “paint” grow in an incubator for two days, and then they take pictures of their work. After they photographed their creations, they disposed of the bacteria through an autoclave process. From a microbiology perspective, this teaches aseptic technique procedures and helps students appreciate how to minimize contamination.
Totem is grateful to every artist and writer who submitted their work this year. The submission pool is open to students in all majors, to faculty across the disciplines, and to alumni.


Adam Chen
When I was little…
I would pour vinegar into my New Year’s noodles
During Chinese New Year.
I miss that taste, I miss the banners we would hang up, And the performances we used to watch on stage.
I remember the cool water that would cascade over my hands,
As I washed dish after dish after dish, Once we had eaten our New Year’s Dinner. I miss that food.
I miss the oranges we would peel. And the dumplings, And braised pork, And meat buns, And even those jars of sauce…with labels I couldn’t read.
I miss the smell of incense, Wispy and smokey.
I miss the way our language danced from our tongues, Laughing and crying one day after another.
I miss the way those old chopsticks fell, And how we’d laugh when someone would drop them by mistake.
I miss the bowl of rice we would set out for our family,
The roasts and meals and flavors of broth.
I miss our Saturday night dinners, And how my mother would tell me to sit up straight,
How my father would clean his glasses, And how my grandparents would bicker and fight.
I miss the games we would play, And the riddles we were asked, Opening red envelopes…hoping for money, To buy a new game or playing cards with.
I miss my brothers, The way their hair looked like mine, And how they sat confidently at our dinner table.
I miss Chinese New Year.
I miss the Spring festival.
I miss my family.
I miss home.
He wore a striped coat with bugs dancing on his cuff links. The Seven Centuries Old Man beckoned me to his side.
Even from this distance, I noticed the trace of red fermentation in his breath.
His palms open and up and down. He spoke loudly with animated gestures. The wife had big eyes, bigger than her big red ballgown.
They wallowed in abundant fields of energy, His shoulders almost lifted him off the floor, bound only to this earth through his heavy heart, dedicated to the woman in red.
However curious I was about him, he was too, to me
And swiftly, he tore me open, exploring. A case study strewn on the floor for everyone to see,
A boulder, stuck and awkward.
I tried to keep myself together as he ripped me apart Without even noticing The red blush on my face from each probing question.
I may still be there, laying heavily on the floor, still thinking of an answer to the questions
he asked me that day of who I am and what I’ll do.
But now, I walk lighter than I did, And so, I wish I could thank him.
Because I would have never been able to appreciate the value of unimportant pleasures, or the simple beauty of the sky,
Without being urged to look up, and away from the burdens that chained me to one place.
Your pace of life reflects itself In the rhythm of your lungs. Panting your way through life, Only to become a hero forever unsung.
Find beauty in what is finite And embrace what is impermanent. It remains true that your time is limited, Yet, for its use, you are the determinant.
Let the moments slip away, dear one, Worry only for what is guaranteed; The present moment is all we have And is all we should ever need.
Slower becomes the rhythm of your lungs As you let yourself embrace peace. Now you can see the beauty in the moment As all of your worries begin to cease.
Third Place, 2023 Gannon Poetry Contest
Seagulls at the beach
Crying and wailing for naught
Sirens in the air
I love the city but it wears on me
Came home to the beach to set myself free
Offering them bread
In exchange for some silence
Make the peace I need
Writing quatrains while the train dashes by Dropping off one-time visitors who sigh
Clouds approach the sun
Challenge the authority
Of the summer light
This town is nothing more than a birthplace
With stubborn storms that only locals face
Rain comes crashing down
I flee to the dry tool shed
Immersed and alone
Writing quatrains while the rain is falling
I hear the sound of my mother calling
Earthly cinema
Nature is a performance
Standing ovation
Jiwan Kim
First Place, 2024 High School Poetry Contest
My father always bought tickets When no one else wished to go places.
Heavy-eyed TSA agents, Beaten down by the fluorescent lights, Weren’t as worried about Sweaty palms or The sneakers I’d accidentally left on.
My father and I parted from their forced company Into the deserted terminal.
I tip-toed through the rectangular hallway, Fearing I would disrupt This theater without an audience. This mall without customers. This sky without clouds.
The woman doused in drab business attire And weighed down by eyebags
Simpered as she flipped through The cardstock pages of The Rainbow Fish.
And my father, scanning through his work files, Enjoyed a refreshing room-temperature Coors Light
Paired with his favorite blue jelly beans.
The silence of The lemon-scented disinfectant
The janitor wiped on the seats, The tingling cold
Hurrying from the vents, The smoothly operating metal escalator
Drumming on through the night, The absence of feet on the desire path Worn into the carpet by dragging heels, boots, and flip-flops.
4:00 AM Tuesday at the airport Was the quietest.
So I cartwheeled down the desolate path. My light-up unicorn sneakers flew off, And my giggles echoed Into the depths of the dreary terminal.
Audrianna Bacik
As a little girl
I dreamed of what the future would look like
I imagined my high school graduation
You’d be there
Tears in your eyes because of how proud you are of me
As I walk across that stage and get my diploma
Looking out into the crowd of unfamiliar faces
Only to land upon your familiar face
I smile
Because I know you’re proud of your little girl
As a little girl
I imagined what the future would look like
You’d be there
I get accepted into the college I want
Once again
You hold back tears because of how proud you are of me
I make the Dean’s list
And you realize
Your little girl isn’t so little anymore
As you sit through another graduation
As a little girl
I dreamed of what the future would look like
You’d be there
Fast forward to my wedding day
I’m nervous and anxious and overwhelmed
You come in and manage to calm my nerves
You say I’m beautiful in my white dress
And walk me down the aisle
You start to cry
You’re giving your only daughter away
I’m grown up now
And I see you in everything I do
Every time I cook
Every time I drive
I see you
I’m grown up now
I look back on all the memories we had together
The ones I have tattooed on me
The one of when I graduated high school
And you got me a card
And you wrote I love you
The one of when I played dice with you
Of the pair of dice we used to play with
Even after you told me it was time for bed
But you let me play anyway
The one when I was cuddled up asleep on you
Of the photo that captured that moment
That I felt so safe in as a baby on your shoulder
Your arms wrapped around me
So careful not to wake me
That little girl in me
Who lost her father
Is still dreaming about what the future would look like
But this time
You’re not there
Her mind is filled with questions
Who is going to watch her graduate from college?
Who will cheer her on?
Who will walk her down the aisle at her wedding?
The little girl in me
Who lost her father
Still dreams of you walking her down the isle
And being proud of her
And she still looks for you in the crowd of unfamiliar faces
Still hoping to find yours
But unsuccessful
That little girl in me
Who lost her father
Hopes she is making you proud
She can’t wait to see you again
Grown up me thinks about when I will see you again
I can picture how it will go
I see you in a place that’s unfamiliar
But at the same time so familiar
Like I’ve been there before
I find you
And everything around me disappears
Everything but you
Time freezes
While I collapse into your arms
Tears stream down my face
As I attempt to get the words out
I’ve missed you so much
I don’t want to let go of you
Your embrace calms me
I feel the warmth coming off of you
As I’m engulfed in the arms that I remember so well
They wrap around me and don’t let go
It’s just as comforting as I remember it
You say
I’ve been watching you
You’ve made me so proud
I smile as I hear your soothing voice
Too happy to reply
I just squeeze you even harder
Hannah Shabala
Second Place, 2023 Gannon Poetry Contest
First sights on a ski trip, a proposal on a mountaintop, and a honeymoon in a blizzard.
First steps and then first ski boots for children follow suit Sunday mornings, each and early, under dawn’s light. A packed car and winding roads Lured by fresh air and powdery landscape
Flat inclines called bunny hills holding on and letting go. Soon we seek trails marked with inky gems Jumping and screaming and racing The wind is our only competitor.
On passionate feet we descend freely and controlled. like the sweep of a fountain pen, white on white we stripe the slope with our signatures, but for only a minute.
At the end of the day, When there are roses on our cheeks we retreat to the lodge.
O Tannenbaum, deep, dark, heavy, leathery, sweet, and smoky
My mind has memorized the spiraling inlays on the thick oak table and it is there where I now sit. The new half holds my attention and in the background
the plague I hear singing, Happy Birthday to you
I pull on my heavy wool socks They were born in the United States and my boo’s beginnings in Austria and my mittens manufactured in China I’ve seen the makings, but not the maker
Outside the tongue of snow licks ski wax and epoxy backs. Spring is just warming Her throat. It would be a nice day for a wedding Wouldn’t it?
The television reminds me… We see them rise with incandescent hearts and motivations so humble
But He has stained his mind with the idea …of falling and so have the skiers and so have I, falling out of my old loves
Today is a birth and a wedding and a funeral. Which would you attend? I have the world we made together, but I cannot see you in it.
We wrote this anthem a century ago but it was inapt on our Father’s lips. Does it ring anymore true today?
Should I ski today when the world is ending.
ripples right before my very eyes, i take a moment to release myself from all that i despise, if it had its intemperate way, my mind would lead itself astray, to its very own demise
ripples as the tears torrent and fall from my face, whenever i feel i am not enough i go to this place, it’s in this space that i look within, so that i might deliver the being i love inside from his chagrin
ripples as i reach deeply into his soul, it is only i who can make me whole, whenever i feel i am not much, spontaneous reduction to a puddle, i turn inward and perceive myself as i gracefully ripple
in these ripples, i will not shrivel, an immediate cessation of the drivel, in these ripples, i instead collect, every reason i must protect, why I am more than much, more than enough, deceived i cannot be, for my ripples have always discerned my bluff, ripples, rippling ever gently, even so, shaping him tough
in these ripples i face resilience, i pay my penance, i embrace thy essence ripples incarnate my shape, and once more, i am loved, i am safe
Kathryn Dickey
First Place, 2023 Gannon Poetry Contest
I saw a scorpion in my bathroom roughly two and a half years ago, though it was not my bathroom, but one that housed my toothpaste and an array of blemish-fighting products. A temporary space–whose mirror I never quite got used to seeing my reflection in. I had finally left the shackles that trapped me in my hometown, one that has advocates who love it through the pits of its deepest potholes.
I stood there, frozen as if hit by a lake-effect snowstorm. It was then, that I knew I didn’t belong here, no matter how much I hated the familiar roads and summer tourists when trying to get a chocolate & vanilla twist on a hot summer day. It was then, I knew, killing that scorpion would set me free of the delusion I put myself in.
I was born to live with chapped lips, to find myself in the place that I lost myself, even if for the rest of my life I plan on partially lying and saying I’m from “north of Pittsburgh” when asked where my hometown was. To smell of cheap vanilla perfume and wearing my father’s old crewneck he bought from an NFL game in the eighties. To be curled up in my temporary bedroom, flipping the fresh pages of a book I bought several months ago that I am just now getting to read—my own epilogue in this place slowly being written as I learn to dream realistically.
I can escape the smell of stale breath tainted with alcohol, trading it for fresh linens on a queen-sized bed, and I can reminisce about the first snowfalls that drown the last of autumn’s colors until the spring, where they dully emerge awaiting the rise of new life. This winter of mine is colder than those of my past. Even the ones I swore hypothermia would stop my heart. Yet, the seeds awaiting germination will be carried far away, hopefully somewhere not infested by scorpions.
First Place, 2024 Gannon Poetry Contest
I am from barefoot games of tag and the squish of muck between my toes, From sticky popsicles dripping across the wooden planks of the little house we pretended was ours, and long ropes attached to the seat that would swing from the old oak tree.
I am from creaky steps, scratched pine floors, and landline phones.
From the strum of a guitar not touched often enough, the clang of tools in the old garage, and the hum of a red tractor on which I took my first ride.
I’m from long roads without yellow lines and the wind blowing though my hair in my Papa’s TR6. From the tops of hills where fields stretched for miles and you could feel Heaven if you lifted your chin high enough.
I’m from a kitchen wafting smells that couldn’t help but make your belly rumble, a well-loved wooden highchair which stood steady for ten messy little babies, and a table that was always full. From thanking my Heavenly Father for the food that sits before me, the family that sits beside me, and the life that lay before me.
From bonfires in the cove at the edge of the yard and making shadow puppets against the canvas that would protect me from the creatures of the night.
From campfire tales and the echo of “Michael Finnigan” as marshmallows drooped off the metal sticks that twisted and twirled above the flames.
I’m from fuzzy kittens that appeared at the end of the driveway, a result of an owner’s neglect but my reward, the bark of a dog in the still air, disappearing into the trails, hidden by tall grass. From learning the perfect “moo” thanks to the Holstein cows at the end of the drive, and how to catch the most lightning bugs, sometimes more than five.
I am from the clatter of dominoes and laughter that I’ll smile about for years. From hearts bigger than this state and a family far too big to possibly sit at one table. I’m from warm arms wrapped around me and love bursting from under the roof. And when I remember where I’m from, I’ll never forget that it is here.
Luke Andraso
In my quiet bedroom, with the window ajar, The summer breeze blows in through the night. Faint pops echo out North; I can tell they are far— A noise that too often fills the community with fright.
A common noise to hear on the Fourth of July— Only these sounds do not come from celebration. They come with the harsh realization That people will die.
On the streets and in masses, this brutality has a range— Gun violence in America is a tragic stain. This state—and our country—needs to change, Too often leaving people in pain.
This is the world too many grow up seeing, People they hold close, living in fear. This nation can change if we believe in human beings, Who work in Harrisburg, Washington, and even right here.
We must not let metal and brass divide— Rather, use it to bring us closer, side by side. So united, as a nation, we can stand tall, To heal this wound—and unite us all.
Luke Bratton
When, into the bucket, the brook trout fell a mysterious bout consumed my mind, Torn from a world it knew so well, its place of habitation left behind, To feed myself (a life of taking), miniscule however it may be I reflect on natural, pastoral, quaking of ebbs and flows, of sea boats shaking.
Thus when I stomp, or assert powers (O’er nature’s bursting brooks and flowers), My empathetic self retreats.
For fish, for birds, for labored meats— For wine, for bread, for glory, salvation!
I do not feel natural in this (outside) nation.
On doom I’ll ponder (weeks of gloom filled slumber (marked by untold Thoughts of twofold plunder—one of discrete overtaking of mind’s operations Boosts of morale, distraught vacations—the second a mode of stealing living)) With no second thoughts or feeling giving I take to survive and breathe One day longer, But oh! To thrive in paradise stronger!
I am a member of this temporal settlement—
I’ve been told, thus believe, nature is unintelligent— Nor is it well to be removed, (unless by law it is approved). Now when I take a life to sustain mine
I am doing a good (so says the Divine), I am so honorably using the earth!
It’s intended use—instrumental worth.
Markus Curtis
First Place, 2024 Gannon Poetry Contest
I like to think you laughed while you fell, your wings set in wax never made to weather the heat of your heart.
You were told the heights you flew towards would spell out your end. You, Icarus, decided the golden rays emanating from the sun called your name. The clouds beckoned, billowing above you. The wind gusted and you flew higher and higher.
I like to think you started laughing the moment your feathers left you Flightless when you felt the wax dripping, your burning skin, nothing compared to the freedom of Flight
Not a chuckle or giggle but a roar reaching out and diving deep into the soul of the onlookers watching who would have felt scared for you?
But you, Icarus, I know you laughed as you fell. Oh Icarus, Oh Icarus they would’ve said.
Clutching a pink plastic pail, heading where rotting leaves lie thick and wet; the best ones are under there – plump and long – sometimes twenty twined together. Fingers plucking; dainty tongs; the pail is a portable penthouse.
Running home to show momma,
Oblivious to burrs in my pigtails, soiled ruffles, and soaked socks. Unaware that my pets are unwelcome.
My soul came back in a box when the cops were through. They knew I read Camus, used contraception, took my Mary Poppins toothbrush, probably sniffed my bikinis. They sent the box stamped “City of New York Police Department” after they decided where I was going and who I should be.
Second Place, 2024 Gannon Student Poetry Contest
I chop the onions, potatoes, and carrot, The colors interlace like a radiant palette. With love, I sauté the onions with ginger and garlic, The pot is overflowing and frantic, I tend to the dish in a panic.
The fragrance intensifies with each oil flicker, My puppy anticipating for a taste with a bicker. I season the chicken with sweet, savory, and spicy flavors. Creating the dish that my brothers most savor.
Once the rice is finished, I prepare the dishes. I set them down and my finger twitches.
I halt and realize I made a family serving, Unknowingly, with my passion burning, I take a glimpse at my iPhone, all alone, In its emptiness, my solitude is known. I look around at this empty apartment, The silence echoes, I am a lonely serpent. One person with a family serving, distant.
One week to reach a settlement. Silence falls over miles of highway for a singular moment.
Cries break the stillness on both ends.
Two months to untangle the knots. The wrangled locks of hair, Now separated with dead ends severed.
Three years are a sinkhole at their heels. As dust and ashes are reclaimed into the earth, They’re exactly where they were yet misplaced.
There’s gossip in the town of someone passing yesterday.
There’s flocking and foraging at the wounds, But they were well scabbed over before the vultures arrived.
Funeral arrangements aren’t made, Nor are floral arrangements to mask the reek of death.
He continues on, seeking a new place.
Afraid of collapsing ground, he runs in oblique paths. He desperately scouts for a place to rest.
Finding a place where no birds chatter, he finally rests in the shade of a willow tree. He finds that the sanctuary mirrors him.
The willow’s bow from blasting wind, his kyphotic spine from accommodation. The willow’s exposed roots from loose soil, his ever-shifting footing from unsupportive foundation.
The willow’s thick bark from resilience, his thick skin from callous.
He breaks off bark to chew, nature’s aspirin. It may ease his sore feet, But it does not treat his aching soul.
After catching his breath, He continues on with no clear direction. His steps mimic those of a waltz.
Three beats, In two movements, And one orchestration of life.
Robert Deal
Bothersome, bellowing, bellbirds, hooted and hollered awakening fellow birds. Bluebird and Redbird flocked to the scene to find the reason behind what they heard
A glorious eagle had been tied and thrown in a ditch, who did this to you the Redbird asked, but the eagle didn’t want to snitch
It was the other eagles, a kiwi shouted, they’re all holding shovels and ropes, but I don’t know which. It must’ve been the crows, the parrots shouted, they always seemed suspicious.
Don’t worry at all we will speak with each and every witness Redbird announced and find out who could be so vicious.
It was the rats that those rude, radical, rambunctious rats, Bluebird told Redbird I always say the truth and I saw them do it, it could only be those rats.
Well congrats said Red Bird, but please don’t shout in my face; I still need to speak to everyone to solve this case
First on the list were the holy parrots, preachers of good and love for all What do you know of the eagle’s fall asked Redbird, can you recall?
We were in temples, the parrots said, we saw nothing, but the crows always do bad things, and we hate those who do bad things, so whenever bad things happen the crows must’ve led I am already ahead Bluebird then said to Redbird, it was those rats, I always tell the truth why don’t you listen to what I said
To solve the case, I must listen to everyone’s story said Redbird, forgive my friend I am sorry
Second on the list were the self-loathing crows, for all the brilliance they had, it was odd they disliked themselves more than anything
What do you know of the eagle’s falling asked Redbird, did you see a thing?
No, we did not, we were all here doing nothing, said a Crow, but I would like to let you think, a man who possesses all the intelligence in the world looks in a clear puddle to find his greatest enemy, that is if he can see anything
At a dead end on the case, Redbird decided to speak to the pheasants, they are normally pleasant. What do you know of the eagle’s event asked Redbird, were you even present?
No, we were busy with our lives said a Pheasant, there is a sick and hungry chicken all around us but we are far too busy to help the stricken, far too busy to notice an eagle trapped in a ditch.
Far too busy doing what?
Well, of course, far too busy trying to get rich
Bluebird then shouted, why are we wasting time? It was the rats!
I even saw them do it, and I just wondered why Fine we’ll speak to the rats, said Redbird followed by a reluctant sigh.
Third on the list were the rats disliked by most birds for apparently no reason. Why did the birds hate the rats?
Their parents, their parents, and their parents hated the rats, to hate the rats had become a tradition, hate for the rats was no longer for just a season
Do you think the other eagles committed treason asked Redbird, were you in the region?
No, we were here fighting an owl, a rat replied, I never knew a bird could be so foul.
My brother was hurt badly while on the sprawl, we only had to fight this battle because our grandfathers decided to brawl, and my very own grandfather came out standing tall, my poor brother suffered the payback from an unnecessary war I know it was you, you evil rats do evil things said Bluebird I saw you do it, I don’t believe you at all The woodpeckers were there at the scene said the rat, It is easy to mistake us, we’re both small
Fourth on the list were now the woodpeckers, who pecked wood all day long Who threw the eagle in a ditch, who do you think could be so strong asked Redbird,
can you help us out this case is beginning to prolong
I’m sorry I cannot help. I spent the whole day wood pecking away, said the Woodpecker its all I do and will ever do, my days are a constant replay Redbird then asked if wood pecking ever, brought any dismay.
Sometimes, but that’s what woodpeckers do said the woodpecker, we spend everyday…woodpecking away. If I were to give some advice I would say go and speak to the vultures if you want to have it your way
Last on the list were the vultures who often clashed with the eagles because of differences in cultures, the vultures of today wanted everything to be all right while the eagles still wanted a fight. What do you know of the eagle’s plight, Redbird asked, were you anywhere in sight?
No, we were all here filled with fright said a Vulture, we’re afraid of the eagle’s terrible might Eagles then appeared out of nowhere
The Vultures began to shake in fear
A vulture shouted to the eagle, why do you hate us so?
An eagle replied because our forefathers dealt each other a serious blow A vulture returned, we aren’t responsible for that
An eagle exclaimed I don’t care for that, I see you no different than an owl sees a rat!
Redbird interrupted the two saying please stop debating, the other birds are waiting, who committed the crime?
The eagle then said just arrest me it’s about time, I’m surprised it took you this long after that Kiwi’s tattletale song
Across the sidewalk, a little girl in a yellow dress leans forward to smell the air above a table covered in marigolds. Her careful fingers reach out, hesitating before she touches a single leaf, and I see myself running to my mother’s garden the second I stepped off the school bus to check on her tomatoes, holding my hands behind my back to keep from plucking just one off the vine and biting into it before my parents said it was time. Down the red gravel pathway, a woman sits at a folding card table, short blond hair, stained overalls, a sign by her typewriter that reads: free poems. I watch her glance up from black keys to the man waiting, watch her capture his being in three lines and then hand it to him with a smile. I cannot stop watching her, and after the next poem, I begin to feel tomato plants climbing the walls of my lungs, vines creeping up the tunnel of my trachea in desperate tangles, leaves bursting on my tongue. So I ask her for my turn. My three lines, printed in faded ink on a torn scrap of paper: she watched for a long time, standing still, weighing the taste of action in her mouth, eyes like two blue marigolds waiting to bloom. The little girl in the yellow dress catches my eye again; she crouches down over a potted marigold, considering it. She looks around once, and then, as if it is reflex, her hand darts out to pluck one of the blooms, hiding it in the pocket of her dress so quickly I almost miss it.
I had a professor who called it the trauma cavern, that place where writers go to confront the things they can’t write about anywhere else. I don’t like this; to me, that seems like the worst place to go. “Cavern” does not sound like something that would have amenities, and I’m not a huge fan of camping. There are probably no s’mores in the trauma cavern. Once I visited a cave in Colorado, and a tour guide took us down past cold rocks to the deepest part of the cave. She turned off the lights to let us experience real darkness, told us to hold up our hands and try to see them while the lights were out, then switched off her flashlight. I still haven’t forgotten my invisible hand inches from my face, nor what I’d lost, even my body there.
your bright blue star, pours in boundary.
She heals, near follows— pierced in heart by persons mortal.
Voice, chatter’d teeth a swallow and me, a thief —stolen moments of self softly spoken.
And if you’d never yet now heard about how one calls and then stops— the comedic sorrow, wailing griever, how bright blue sphere keeps calling down.
As square shaped abyss—divinity far recedes spirit, purple in me.
Speak freely, God-Man, and take back Spirit; my lungs collapsed in demons’ closure, for lately given: voice, in exhale. My body long committed, tired.
Shane Davidson
The air was cold, leaves and trees blowing in the wind.
The smell of firewood smoke and early morning rain.
You could feel the heartbreak of everyone who surrounded the casket.
We were saying goodbye to more than just my grandfather
We were saying goodbye to a legend.
As the man spoke it seemed as if no one could hear him, With all the noise, it felt silent.
The touch of wind burns on our faces, Everyone with runny noses and tears in their eyes, It was time to say goodbye forever.


Joseph Dietz
Mrs. Goncharova groaned and paced the hall outside of the room.
“Seven hours,” she muttered to herself, “seven stinking hours!”
Actually, it was closer to nine hours since the movie’s conclusion, but the critics were still arguing about it, and she could hear no signs of stopping.
“Seriously,” she fumed to herself, “the longer they spend chattering, the longer I have to wait to clean the room so I can go home.”
Mrs. Goncharova lived in the USSR and worked as a janitor for her local workers’ club. Today, the fifth of April in the year 1975, was a special day for the club. It was offering an exclusive screening of Andrei Tarkovsky’s Mirror to a select group of prominent film critics. Tarkovsky himself would be in attendance to answer questions and explain his film.
While a dream come true for the critics, it had been a nightmare for Mrs. Goncharova. To start with, she had to arrive extra early at the club to prepare for this special screening. It was snowing monstrously outside, and her old coat was quite threadbare. Once she arrived, she was immediately put to work, with little time to recover from her snowy ordeal. She cleaned the entire club from top to bottom, and the special screening room twice, but still, her work was not finished. “The club must be immaculate for our honored guests and immaculate again once they leave,” the manager had instructed her. Ordinarily, she would have had help, but since the club only needed one room for this screening (the rest of the building being shut down for the day), Mrs. Goncharova had been called to work by herself to save costs. And a lot of thanks she had gotten! All of the critics had blundered into the club, grumbling to each other about the current state of Russian cinema and not paying a scrap of attention to the old woman still working with her broom.
Tarkovsky himself had arrived late, but that was no problem since everyone had expected him to do so anyway. Tarkovsky, you see, was something of a controversial figure. He was known for his slow, meditative, and occasionally graphic films. In Soviet Russia, this branded him as a rebel, and a pretentious one at that! In a few years’ time, the government would force him into exile where he would ultimately die of cancer. But enough about him.
Mrs. Goncharova had greeted the grim-faced director as he walked in, even holding the door for him, but did he thank her? Nyet! He had merely grunted and continued on his way. The elderly janitor was offended, but she could understand if he were only grumpy because of the cold. However, she quickly noticed that this was just Tarkovsky’s way. He was similarly rude and dismissive to the manager, who—lucky bastard— retired to his comfortable office as soon as he had directed Tarkovsky to the theater room. While the movie was playing, the critics had lounged in their chairs, but Tarkovsky had stood off by himself in a corner and scowled. Then, once the film had finished, he refused to hear any of the critics’ questions or takes, stating that that they were too “secular and material” to appreciate his “masterpiece.” So, the critics had talked amongst themselves, and, although Mrs. Goncharova hated to admit it, Tarkovsky was right: they simply did not understand the film.
Now, as much as she was coming to hate Tarkovsky, Mrs. Goncharova was also starting to feel a bit sorry for him. It was a shame that no one could understand his film. She had snuck into the theater room while the film was playing, and while its nonlinear, almost poetic narrative had completely baffled her, she did have to admire Tarkovsky’s artistry. He had clearly put a great deal of work into the film, and, at times, it was quite stirring and beautiful. Mrs. Goncharova had especially loved the scene of a young girl warming herself by a fire. Tarkovsky had angled the camera to make it look as though the girl cradled the fire in her hands, with the flames aligning themselves across the lengths of her fingers. And there was that young boy, Aleksei, watching her…
“He looked like my Fyodor,” whispered Mrs. Goncharov to herself. It had been years since Mrs. Goncharova had last seen her son. She had felt so much potential in him, even before he had been born. Mrs. Goncharova had struggled to conceive him, so she took his birth as a miracle, and she tried to raise him as such. She named him after the great Russian writer and mystic, Fyodor Dostoevsky, hoping that Fyodor Goncharov would grow up to be a “saint” just like his namesake. Sadly, as with all good things, it proved too good to be true. The two had drifted apart over the years, with Fyodor becoming increasingly distant because of his arrogance and his mother’s shortcomings. Now, to be fair, she had
many, but they were hardly her fault. Her husband had died during the Second World War, leaving Mrs. Goncharova, pregnant with little Fyodor, to raise him on her own. She worked long days and often nights as a janitor at the club, leaving her little time to spend with her little boy.
“Just like Aleksei’s mother in the movie,” she thought, and her mind raced back to an early scene from Mirror. Even now, she could vividly see his mother sitting on that fence with a cigarette, watching the cloudy blue sky and waiting for her husband to return. She could see her crying as she accepted her fate. She could see that woman’s entire house come crashing down around her in a flood of emotion, loss, and rain. He’d left her behind, and it seemed he was never coming back.
“So much loss in that movie, just like in real life. Everyone loses everyone, no matter who they are, friends and family, all alike,” she murmured. Then she gasped and thought for a moment. “What an awfully poetic, no, pretentious thing for me to say,” she thought, “Tarkovsky’s rubbing off on me.” She shivered.
Although she tried to avoid thinking about it, she really was completely alone at this point. Besides the death of her husband, all her closest friends had left her by now. She didn’t care why or how they had left, whether it was moving for work, fleeing the country, or simply passing away. It made no difference; she was alone.
“I guess Fyodor was alone too. He was always so close to their children, and I never really thought about how their leaving might have affected him,” she thought. “Really, looking back, that’s when he started closing himself off. When his friends started leaving him.”
Fyodor had grown so disturbed during their final years together. He had always been a laconic yet strangely rebellious child, but as time passed, he had grown more withdrawn and even vicious. He would often come home late at night while she was asleep, and if Mrs. Goncharova saw her son during the day, he would only mutter threats to her about a “coming reckoning.” Mrs. Goncharova began to suspect what was wrong, but she was growing tired of her son’s behavior, so she remained silent. One fateful day, she received the awful news: Fyodor had been
arrested for his involvement in an anti-Soviet revolutionary circle. The circle had launched an insurrection in December of 1966, but like any inside attempt to overthrow the Soviet Union, it had failed. Fyodor was the lone survivor of the circle, with all other members killed during the fighting. For his crimes, Fyodor Goncharov was sentenced to a prison camp in Siberia, and he was sent off before his mother had a chance to say goodbye. Though the authorities had offered her the chance to write, she had never taken it, for she believed that he still hated her.
“Aleksei felt the same way about his mother,” she thought. “During that phone call scene, they can’t look past their pride, and a mother hangs up on her own child.” With her son gone, and for all she knew, dead, she understood that she would soon die alone too, just like the sick Aleksei at the end of Mirror.
“And just before he died, he released that bird in his hand,” she thought, “I can’t even begin to imagine what that was supposed to mean, but right after that, we’re back with his mother and his father, and his father asks his mother if she wants her baby to be a boy or a girl. She thinks for a moment, kind of looks into the distance, and then we see her, looking much older, leading the protagonist and his sister along. The little girl is holding her mother’s hand, but the little boy is running all over the place. Yet no matter how far he runs, he always comes back to his mommy...”
She started to cry, but a sudden burst of cruel laughter from the room tore her from her musings. She peered inside and saw one of the critics imitating the Spanish dance from the movie. She stole a quick glance at Tarkovsky. The director was still off in his corner with his head bowed. “Probably angry,” she thought. But upon looking more closely, she saw his eyes looked more hurt than wrathful.
“Excuse me!” someone shouted. Mrs. Goncharov gasped and realized the shout had come from her. “Excuse me,” she repeated more softly, “it’s been over seven hours, and I really need to clean this theater so I can go home.”
The critics turned around, and Tarkovsky raised his eyes. “Well, I’m terribly sorry, comrade,” said the critic who had been dancing, “but we
haven’t uncovered the hidden wonders of Andrei’s masterpiece just yet.” Several of the critics tried to stifle their laughter or pass it off as coughing, but they failed miserably. Looking at Tarkovsky, Mrs. Goncharova could see that he was properly furious now.
“And to be quite serious, comrade,” added an older critic, “we truly don’t understand his film. I for one believe there is some greater meaning behind it, but for now, it’s beyond any of us.”
“If there is some greater meaning,” chuckled the dancer.
“But why don’t you understand it?” asked Mrs. Goncharova. “I snuck into the theater to watch it with you, and I understood it just fine.”
The critics and even Tarkovsky were taken aback. They looked around the room at each other in silence for what felt to Mrs. Goncharova like an eternity. Eventually, the dancing critic smirked and asked her, “Is that so? Well in that case, what is the film about?”
Mrs. Goncharov blushed and stammered a bit before responding, “I-It’s about an old man’s memories on his deathbed. He’s pushed away everyone who’s ever loved him, and he’s been afraid to apologize. Now it’s too late, and he’s going to die alone.”
The critics, even the dancer, were taken aback. They stared at her, but Mrs. Goncharova could not tell if it was with amazement, disgust, or ridicule. Suddenly she felt someone’s arms around her, and she heard the critics gasp. She looked up and saw Tarkovsky’s crying face. “The old woman is right,” he growled at the critics. Then he leaned down and whispered into her ear, “I never thought of it that way, but that’s exactly right. I’m so sorry.” Mrs. Goncharova broke down and began to cry too, and they spent the next eternity holding onto each other until the poor janitor could cry no more. After Tarkovsky released her, he stepped out of the room and motioned for the critics to do the same. They soon followed after him, leaving the old woman alone in the theater.
One final eternity passed. Mrs. Goncharova looked up at the screen, smiled to herself, and eventually, she left too.
While some of my peers grew up on iPads and Disney vacations, I spent my summers swimming in mud and bathing in dirty water. The outdoors is a way of life for me. It is where I am most comfortable and free, where I can be myself without any fear of judgment from the wandering eyes of God’s creations.
There is a small creek adjacent to our house and that is where my sister and I spent the majority of our springs, summers, falls, and winters while we were growing up. By small creek, I mean miniscule, virtually a puddle. It slowly flows over slime-covered rocks, water skidders and damselflies lazily hovering over the water’s surface. The open field to the west usually offers a cool breeze to come through, but the scarcity of thick foliage allows the sun’s magnificent rays to shine through, warming the water and creating an oasis. It is the most peaceful place I know. Sometimes when I’m down there, sitting on a rock or lounging in the hammock, I close my eyes and just listen to the sounds of nature. Birds sing their sweet songs of summer, water trickles over the small manmade waterfall, the peepers, those invisible but mighty frogs, croak and the chorus of their music fills the air, drowning out the drilling sounds of cars whizzing by on the nearby main road.
The water felt heavenly in the blistering heat of the summer sun, and below the surface, minnows frolicked among the rocks and water reeds that lined the bottom of the creek. Dragonflies floated around, painting the water with flashes of blue, green, and black. It wasn’t very deep, only a few inches, but as a child, it was wild, something belonging to nature. My younger sister and I spent hours upon hours down at the creek, flipping over slimy, moss-covered rocks looking for crayfish and frogs and climbing vines that hung from the trees which overlooked the water like gargoyles, protecting our sanctuary. It was the most serene place I had ever known. The creek was my lifeline through many hardships in my life, the sound of trickling water pumping consolation and reassurance into my brain the way the heart pumps blood and oxygen throughout the body. I hid there when my parents battled out their divorce. I cried there when my dogs died. I sat there blankly when the person whom I thought I
would spend the rest of my life with abandoned me. It was my safe place, the leaves on the trees a blanket, nature’s protection.
One of my favorite memories of spending time down at the creek is all of the fires that my sister and I used to make. We were (and to be quite frank, still are) a couple of pyromaniacs. It’s probably a miracle we didn’t turn out to be arsonists given how much we enjoyed playing with fire.
They always started out the same: a pile of notebook paper, a decrepit pyramid of sticks and leaves, and a lighter that we snuck out of the drawer in the kitchen when our mother was not looking. Our parents always told us that if we played with fire, we’d pee the bed, but we never listened, and our sheets remained dry.
Once in a while, we would get so caught up in our miniature bonfires that we would forget to go back up to the house to use the bathroom. We were those feral children who would squat behind a boulder or tree and wipe with a leaf rather than take the time to trek up to the house. It was perfection for us, though. We had absolutely no shame in relieving ourselves outside. We’d been doing it for years. If it meant we could spare five or ten minutes from being in the house, it was entirely worth it. We enjoyed nothing more than the time we spent at our beloved creek.
The two of us envisioned ourselves in an existential battle against a fastshrinking world. We did, and pretty much still do, everything together. It was very rare that one of us would go outside to play without the other, unless of course we were fighting. Being close in age—she is thirteen months younger than me—was both a blessing and a curse. Jess was always too old for me to boss around like a toddler, but I tried to anyway. Sometimes she let me, and other times we would fight over who got to be in charge of the day’s adventures. Our squabbles were often verbal, but once in a while we got a little physical, catfighting with half-hearted swats at each other. In the end, though, none of it was more important than the love we had (and still have) for each other, which was noticeably on display when we explored what happens when fire meets wet rocks.
You see, we were smart kids. We made a firepit out of rocks next to the shallow water of the creek. There was never a worry that the blaze would
get out of control because we were very careful to keep a bucket on the shallow shoreline of the creek. One day, however, we had gotten some new rocks to restack our firepit and didn’t realize that although their outsides were dry, some moisture had been retained further within.
Jess and I decided to begin leaning sticks against each other. Our beloved dogs, mother and son yellow labrador retrievers, supervised our endeavors, always careful to keep a close eye. Sampson, the son, loved fires. He was so content to be with us next to the fire that he paid no attention to the heat that had gotten a bit too close and singed the fur on his tail.
Once we had collected enough mangled sticks, we constructed a pyramid and began stuffing it with paper. Satisfied with our work, one of us, I can’t remember who, took the long, purple Bic lighter and set the structure alight. Sometimes our fires took right away, but other times they struggled to stay lit, and we went through an entire bundle of scrap paper trying to keep them going. This one had no issues. When it was steadily roaring, we added bigger sticks and even some logs from the woodpile behind our house.
After a while, we started hearing what we thought was the familiar snapping and crackling of wood under immense heat. We were poorly mistaken. The sounds we were hearing were actually the exploding of wet rocks that were a part of our firepit. The stones cracked and took flight, some landing several feet away from the roaring inferno. We were scared at first, not knowing where the projectile rocks would land, but then shock and a mad pleasure took over our brains and we cackled at the chaos in front of us. Stones flew in every direction; it was like the world’s worst game of hot potato. There’s a saying that goes, “It’s all fun and games until someone gets hurt,” and apparently not even detonating stones could deter us from our love of fires.
Later on, we asked our mom why the rocks had exploded and she told us that it was from the water inside of them causing rapid expansion. It didn’t make sense to us at the time, but it was cool and we decided that we would play with them again.
I know we sounded like future serial killers, but being raised in the woods gave us a ridiculously morbid amount of curiosity, and projectile stones were just the tip of the iceberg. We thought nothing of examining an animal carcass out of nothing but natural wonder. We’d ask our mom, “what bone is that?” or “what do you think killed it?” A lot of people might take that information and judge us to be cruel, but Jess and I were just fascinated by everything in nature and wanted to know as much as we possibly could.
I will never regret the way I was raised, especially considering the fact that I, a girl, was raised to love the outdoors. People would say, “playing in the dirt and riding four wheelers is for boys,” but I’m not someone who wears makeup or takes an hour to decide what clothes to wear or how to style her hair. I could spend all day watching birds or catching frogs and salamanders in the small, shallow pond behind my house. Riding four wheelers and getting filthy dirty while doing it is my ecstasy. I am a part of nature as much as leaves are a part of trees. We go together hand-inhand, and I would not change it for the world.
It was the archery season of 2021. Typically, my choice of hunting location was somewhere in a tree stand, but that particular day I decided to go out behind my house and take roost on an old tree stump. It was nothing special. In fact, it was wet from damp moss, covered in leaves and tree debris, and barely large enough for me to comfortably sit on. The stump sat about ten yards from the old four-wheeler path that had been such an essential part of my childhood. We’d spent hours riding through the woods with the wind in our hair and, usually, mud on our faces. Nestled between either side of the rows of pines, that path may as well have been our path to heaven.
Archery season is the best hunting season. There are many reasons for this. One being that it is a lot quieter than any variety of rifle season. Near where I hunt, there are very few archery hunters. It is rare for me to encounter someone else in the woods during this time. When there aren’t constant gunshots, it is a lot easier to hear the snapping of twigs and brush of leaves against an animal’s feet. Squirrels sound like
elephants. Turkeys roosting sound like pterodactyls (yes, they actually do, it’s horrifyingly loud). Deer are honestly the quietest of all the woodland creatures I usually see.
The other reason I love archery so much is because of how peaceful it is. I can’t really explain it, but there’s something serene about being in nature for hours on end, just watching and listening. It gives me a lot of time to think, and when I’m done thinking, I go back to taking in the beauty of God’s world around me, and the fact that He created the creatures that provide me and my family sustenance. Even on days where the only deer I see are either too far away to shoot or not within my legal range, I am still uplifted just by being in the same presence as such magnificent creatures.
Anyway, on that one fateful day, I had taken a seat atop the old, rotten stump and sat there waiting, bow in hand. There wasn’t anywhere for me to hang it, and being so close to the ground meant that I was at eye level with my prey. I couldn’t afford to get caught trying to pick my bow up off the ground. It was a beautiful day. The sun was shining down through the trees, casting shadows of all sizes across the crunchy, decrepit leaves that littered the ground. Although it wasn’t overly warm, I was comfortable in my thick camo hunting coat and pants.
I sat on that stump for a couple of hours, watching and listening to the sounds of nature around me. A woodpecker off to my right made quite the ruckus as it pecked and pecked its way through a dead tree, looking for bugs to eat. Various species of squirrels surrounded me, stirring up leaves and scurrying through the trees. I could hear turkeys gobbling up over the hill to my left, looking for the perfect spot to rest for the evening. It was so peaceful, so serene.
As the sun began to set, it got harder for me to see properly. When I’m in the woods, and only in the woods, my eyes do not adjust well to darkness. I have a hard time distinguishing the shadows from their makers. It’s actually quite interesting, because my mom, who taught me just about everything I know, is the opposite. She can sit in the woods until it is nearly pitch black outside and still be able to see well. This day was just like any other, though. The darker it got, the harder it was for me to see.
When this happens, I have to rely primarily on my ears, which is why I didn’t see the young buck in front of me until I heard him.
Across the four-wheeler path there was a small, basket, six-point buck, probably only a couple of years old. On sight, I froze. It’s hard to explain, but in scenarios like that one, I have this ability to completely alter my body. My breathing becomes slow and silent. I can be in the most uncomfortable position, but I’ll hold it as long as I have to in order to not move, only moving my eyes. That was what I did in this case.
The buck was only about ten yards away from me, but between my camouflage and the cover scent that I had sprayed, I was invisible to him. I thought for sure that at one point or another he would scent me and run, but I was happily mistaken. He stepped closer and closer, not even looking at the human form that was right in front of him. I was both exhilarated and terrified. I knew that it would only be a matter of time before he figured out I was there, and I took in every second I could spend just watching his graceful canter.
I sat on that stump not daring to move a muscle. My bow was still in my hand, but all intentions of hunting had flown out of my mind. One, there was no possible way I could have pulled it up without spooking him. Two, I was completely mesmerized that he was that close to me. In all the years I had spent in the woods, that was the closest I had ever gotten to any live animal. It was all I could do to just sit still and watch the creature in front of me. The deer walked closer and closer, relaxed as could be. I couldn’t believe how close it was. At the peak of my encounter, it was within arms’ reach of me. I could have reached out and touched him if I’d wanted to. Despite the dim light around me, I could see his long eyelashes. His eyes were a deep brown, so dark they were almost black. It was the most incredible experience I’d ever had in nature. One of the jumpiest creatures in the woods was right next to me, and had no knowledge of my presence.
An experience like that one is something that can change a person’s views on hunting, whether for good or for bad. For me, though, it only helped to further cement my beliefs. I have an immeasurable amount of respect for all animals, but especially deer. The are beautiful creatures
and are incredibly resilient. My family and I do not hunt them for sport, only for food. We use every part of them that we can, and only kill what we need. Nothing more, nothing less. I myself am very picky about what kinds of deer I shoot; I prefer bucks because they have no fawns, but occasionally I will shoot a lone doe just to help with population control. The deer I hunt experience no suffering, and their deaths are much more humane than farm animals that come from a slaughterhouse or deer that get hit by cars.
Anyway, the deer eventually meandered behind me and strode off. I listened to his footsteps until I could no longer hear anything, and it was only then that I decided it was safe to get up and get out of the woods. I love being in the woods during the day, but I honestly get nervous once the sun goes down. Ordinary noises rattle my bones and my imagination has a way of turning shadows into monsters. Some part of me was also scared that he was still hanging around where I couldn’t see him. Although getting attacked by a buck is rare, it does happen sometimes, and I wouldn’t have stood much chance by myself in the dark. Whenever my hunt is over and I am leaving the woods, I always make a point to make as much noise as possible to scare off any unwanted company. And as I walked out that night, the only sounds I heard were those of my feet crunching on the leaves below.
To this day, the encounter with the deer is probably the most memorable experience I’ve ever had while hunting. I still look back on that day and try to picture it again, but nothing will ever be as clear as the actual experience itself. Since then, I’ve had a much larger appreciation for getting close to deer while I’m in the woods, even if I’m just in a tree stand. Looking down on them is a fascination all on its own. One of the biggest rewards a hunter can get is being eye to eye with the animals we have so much respect for, and I can only pray that someday I will get the opportunity to do it again.
Hunting is not a sport to me or to my family; it is our way of life. We hunt to provide food for ourselves throughout the year; we freeze the venison for use instead of buying beef products from the grocery. Sometimes we process the meat ourselves, but usually we just take it to our local butcher. I do not view deer as simple game animals—I view them as sustenance,
as necessary for life itself. Every time I harvest one, I thank it for its life and providing food for my family, a sort of ritual connecting meaning with the death of the deer itself.
I learned everything I know about deer hunting from my mom. She has been hunting since she was around my age, and over the course of her adult life she has learned many skills, tips, and tricks in order to become self-sufficient in the woods. I remember begging her to take me hunting with her even when I was a small child. She didn’t let me go during deer season until I was about twelve (rightfully so, because a tree stand plus a small, noisy child equals no deer in sight), but she would take my sister and I turkey-hunting in a ground blind when we were only four and five years old. As I got older, I was inspired by her passion for hunting, and eventually found my calling in it, too.
I am twenty-one years old now, and just the sound of crunching leaves in the woods gets my adrenaline going. I have gone out hunting several times this year, and most recently, I was able to tag a large doe on the opening day of rifle season. The sun shone brightly in the cold morning air, and after I took the shot and located her, I placed my hand on her head, looked into her eyes, and once again showed my gratitude for this deer’s life. It takes a lot of respect to hunt. For me, it is even more difficult because I truly don’t enjoy the act of killing another creature. I believe all life is sacred and should be respected even in death. Knowing that I have utmost admiration for such beautiful animals, though, is what allows me to appreciate them a lot more than the average hunter. After all, the circle of life exists everywhere, and we must always remember that in the end we are dust, and to dust we shall return.
Thomas Caulfield
“What did I just see?”
James glanced up from his fantasy football article and then back down again. “Calm down.” he said. But I was sure that I had seen that dark shape descend over the man like macabre veil. I was sure that James wouldn’t listen to me as long as he was still scrolling. Another customer entered the cafe, passing beneath the rearing horse which leaped over the words “Charon’s Crossing.” This time I would watch him carefully as long as he was in the shop.
The man approached the shelves and I tried to track him through the windows as his image weaved in and out of the signs on the window. The sweat dripping into my eyes kept making me blink. I was afraid the heat of this July afternoon might stop me from being the private eye I needed to be in this moment. But through it all, I didn’t miss a single movement as he walked around the store, considered his options, and then approached the counter to pay. Sure enough, as I predicted—as James had refused to acknowledge—when the man paid, a cloud, a fog, a haze, something seemed to darken and obscure him. “I definitely saw it this time!” I practically screamed at James. He didn’t seem to care.
Leaving the bench, I moved to track this customer.
He turned left. So did I.
He went up the stairs towards City Hall. So did I.
He cut through the alley before climbing the stairs to a building with signs offering room and board for $150 a day. So did I.
He didn’t pay but entered a room without acknowledging the receptionist seated behind the counter. I followed him.
Somehow, through all this, he hadn’t noticed me. My motions had been silent and subtle enough to evade his attention. I was determined to see what would happen to him. I stayed in his room through the rest of the evening and the night. He slept. He awoke. He left the room again. Nothing changed, not even the swoop of his hair across his forehead.
Frustrated, I returned to the bench to find James still there. Still sitting by my side. Still reading his article. I stood on the edge of a walled garden across the street from James and stared at my neatly curled shape sitting at his side. I must have fallen asleep. I must have been dreaming. But then I watched as James got up and left and I followed him, heading for home. Neither of us seemed to notice that I was standing there watching us walk away. Just as the man I spent all night following had failed to notice. But then, as we were walking away, I turned away from James’ side and glanced back towards myself sitting on the garden wall. I looked right into my blazing green eyes, into that vertical slit of my pupil and I knew that I recognized myself. I could see myself shrouded in that dark veil that I had seen enveloping the customers of the shop marked as “Charon’s Crossing.” I realized that I had undergone the same change they all did. I hope I can still eat tuna.









Amaan Khan













Derek DiMatteo





Emma Russi


Genevieve Preston








Julie Ditz


Lynn Porter








Madelyn Bohrer


Nomuunchimeg Ganzil

LUKE ANDRASO is a junior at Gannon and his major is Public Service and Global Affairs. He is an Erie native and a currently a team captain for the Gannon Cross Country team. He has always loved writing and this is the first time he has ever submitted anything with the hopes of it being published.
MADISYN ANTOLINE is currently a Junior in the 5-year Physician Assistant program and is from Pittsburgh, PA.
AUDRIANNA BACIK is a senior Criminal Justice Major with a minor in English. She minors in English because she loves to read and write. Her favorite thing to read and write is poetry.
CHASE BELL is a senior biology student at Gannon University who will be attending veterinary school in Fall 2025. He loves taking pictures in his free time of people, animals, and landscapes.
MADELYN BOHRER is a class of 2024 Journalism and Communication Major with a Minor in Digital Media.
MELISSA BORGIA-ASKEY, PH.D., teaches in the English and Education departments at Gannon and has over 20 years’ experience in education. Her consulting work has included research and data transcription for the Seneca Nation of Indians’ Tribal Historic Preservation Office, as well as work at a Seneca school, Ganöhsesge:kha:’ Hë:nödeyë:stha, where she has been involved in several projects pertaining to language maintenance and cultural revitalization.
LUKE B. BRATTON ( ’24) has a bachelor’s degree in philosophy and English (literature track) from Gannon University as well as a career diploma in wildlife and forestry conservation. In his free time, he enjoys walking in nature, reading, writing, and exploring different places on the East Coast.
IZAAK BRYSON was born and raised in Erie County. He is in his third year here at Gannon, majoring in Global Cultures and minoring in Arabic Studies and Political Science, with the (tentative) aim of working in academia. He has had a passion for creative writing as a whole since elementary school, and his passion for poetry began to develop in high school.
ADAM CHEN is a LECOM 4+4 Program Student at Gannon University. He is a Chinese American and from Buffalo, New York with an interest in writing as well as drawing and other artforms. He is studying to become a psychiatrist in the future.
SHANE DAVIDSON is a Sophomore in Applied Exercise Science.
ROBERT DEAL is a freshman from the Bahamas majoring in economics who enjoys writing poems, studying history and cooking.
JOSEPH DIETZ is just a humble Mathematics Major trying to make his way in the world of creative writing.
DEREK DIMATTEO is an Assistant Professor in the English Department of Gannon University.
JULIE DITZ is a sophomore PA major here at Gannon who has loved taking photos since she was in kindergarten. She finally got her own camera this year and is excited to explore photography more in the future. She hopes you love her work as much as she loves creating it.
NOMUUNCHIMEG GANZIL is a Graduate student in Strategic Communication
NATHAN HABURSKY is a senior nursing major here at Gannon. After he graduates, he will be working as a graduate nurse on an inpatient cardiac-neurology intensive care unit. This was his first time submitting my work to Totem and is still fairly new to writing poetry in general. He does not necessarily write about specific themes and finds himself writing when something in his day-to-day life inspires him. He is very grateful that he took this final opportunity to share his work before graduating.
SARAH HALPRIN holds a BA in English from Allegheny College and is currently a graduate student in Gannon’s Clinical Mental Health Counseling program.
CADENCE HOOVER is a junior Political Science and Writing major who has grown up in Erie, PA.
E SHANNON HUGHES is a full-time faculty member at Gannon Ruskin in the Dept of Physical Therapy and a part-time amateur artist.
AMAAN ATEEQ KHAN is a graduate student majoring in Business Analytics.
DR. CHET LAPRICE is the operations manager for Gannon University’s radio station, 90.5 WERG. After graduating in 1992, Chet worked for many years in commercial radio before coming back to Gannon, running WERG while earning a master’s degree in business administration (2011) and a Ph.D. in Organizational Learning and Leadership (2023). In 2014, 90.5 WERG was named Best College Radio Station in America. Chet serves on the board of the Intercollegiate Broadcasting System, an international college media consultative organization.
DR. SARAH LIVICK-MOSES earned her B.A. in Literature and History from Hellenic College, a Master of Theological Studies at Boston College, and holds a PhD in Systematic Theology from Boston College. Her primary research fields in systematic theology include spirituality/ mystical theology, Trinity and creation, and questions of gender/sexuality. She also works at the intersection of trauma studies and spirituality, particularly engaging collective trauma with political theology from an ecumenical perspective. Dr. Livick-Moses has previously published her poetry at Macrina Magazine.
SOPHIA MESSENGER is a junior English major with a Spanish minor from Union City, PA.
HUY NGO is a senior majoring in Journalism and Communication with a deep passion for exploring various forms of art.
LYNN PORTER is a second-year graduate student in the Master of Athletic Training program. She has enjoyed capturing her view of the world via photography for many years, and believes photography is one way to find beauty in the mundane. Lynn will be graduating from Gannon this spring and is grateful to those who made her two years in Erie memorable.
GENEVIEVE PRESTON is a third-year student doublemajoring in legal studies and English.
M. GARRETT ROTH is an associate professor of economics. He’s been making non-representational collages for approximately twenty years because he keeps finding tatty, old books and magazines that he doesn’t want to throw away.
EMMA RUSSI is a nursing major at Gannon University who is very passionate about anything science or artistic. Art was always a good way to express herself and release any stress that came her way. Part of the Schuster Scholars with a love for graphite visual art, she loves being a part of this amazing group as it allows her to still have the drive to make new art pieces while having a big work load that comes with a nursing major.
GRADY SMITH is a current 5-year Physician Assistant Major in the Class of 2027 who loves art. He is a member of the Gannon University Concert Band as a Trombone and enjoys expressing myself in his free time with the guitar. He began my photography journey on campus with black-and-white film through Gannon’s Photography 101 course.
PHUONG THAO is a freshman in the Marketing Major who loves capturing quiet moments in everyday life—the ones we don’t always notice. Thao believes beauty exists in everything and likes finding the meaning in those details. Thao sees emotions and stories even in stillness.
DAYONNA SWANSON is a third-year physician assistant student from Erie, PA.
KRISTEN WALLACE is a Junior Physician Assistant student.
Totem 2025 was designed by Andrew Lapiska, Director of Marketing and Communciations.
The cover art, “Mohtarma Zaalim,” is an actylic painting on canvas by Amaan Khan.
This year’s Totem artwork is comprised of acrylic painting, collage, digital photography, pencil drawing, and watercolor. Artwork was reproduced in CMYK builds.
Headline text is set in Madawaska and body text throughout is set in Kopius.
The cover was printed on 100# Anthem Plus Satin and internal pages were printed on 80# Accent Opaque Smooth Text.
The layout for Totem was created with Adobe InDesign CC 2024; photographs and artwork were prepared for publication with Adobe Photoshop CC 2025.
This journal was printed and bound by the Gannon University Press with the assistance of the Totem staff. The cover was die-cut by McCarty Printing, Inc. in Erie, Pennsylvania.
Funding is provided by Gannon University. Totem is distributed free of charge.

